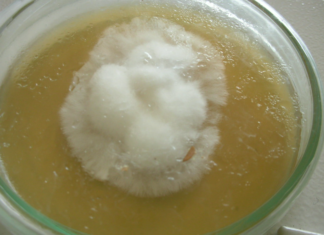

ხველის სამკურნალოდ, სპეციალური სიროფების ნაცვლად, თაფლისა და ბანანის ნარევს ვიყენებ. ეს საუკეთესო პრაქტიკაა ჩემს...
შემოგთავაზებთ ბუნებრივი ინგრედიენტებით მომზადებული სამკურნალო ნარევის რეცეპტს, რომელიც კურნავს ხველას, ბრონქიტს, ყელის ტკივილს. გარდა ამისა, მოცემული საშუალება დაგიამებთ კუჭის ტკივილს.
მოსამზადებლად უმარტივესი ნარევი ძალიან გემრიელია და სიამოვნებით სვამენ ბავშვები.
საჭირო ინგრედიენტები:
ბანანი (მწიფე) 100 მლ
თაფლი...
ტუტე წყალი საუკეთესო რამაა თქვენი ორგანიზმისთვის. წმენდს სხეულს, ახშობს ანთებას, გვავსებს ენერგიით და არა...
ტუტე წყალი გამოდევნის ორგანიზმიდან ტოქსინებს, აფერხებს დაბერების პროცესს, არეგულირებს pH დონეს, საუკეთესო საშუალებაა ქრონიკული დაავადებებისა და კიბოს პროფილაქტიკისთვის.
ყოველდღიურად ერთი ჭიქა ტუტე წყლის მიღება ძალიან მნიშვნელოვანია ადამიანის ჯანმრთელობისთვის. ის დაგეხმარებათ ორგანიზმის მჟავე-ტუტოვანი ბალანსის აღდგენასა და...
თაფლისა და ხახვის ნარევი უებარი საშუალებაა ხველის სამკურნალოდ. ყველას გირჩევთ
თაფლითა და ხახვით მომზადებული სიროფი ხველის საწინააღმდეგო უებარი, უმარტივესი და ეფექტური საშუალებაა, რომელსაც აქტიურად იყენებდნენ ჩვენი დედები და ბებიები. ინგრედიენტები ყველასთვის ხელმისაწვდომია და ნატურალური.
ხველის საწინააღმდეგო სიროფის მოსამზადებლად დაგჭირდებათ შემდეგი ინგრედიენტები:
ნატურალური თაფლი 2-3 ს....
როგორ მოვამზადოთ კიევური ტორტი ,,აკილენჟა”. სიმსუბუქითა და საოცარი გემოთი გამორჩეული დესერტი
შემოგთავაზებთ უგემრიელესი ტორტის, ,,აკილეჟნას“, რეცეპტს. ,,აკილეჟნა“ კიევური ტორტის მსგავსია. პირადად მე საოცრებას ვეძახი და უბის წიგნაკშიც იმავე სახელწოდებით მაქვს ჩაწერილი.
ნაზი, ჰაეროვანი და ხრაშუნა დესერტით ყველას გააოცებთ და აღაფრთოვანებთ. მართალია, მომზადებას დრო სჭირდება, მაგრამ ღირს...
მანდარინის ბაზაზე მომზადებული ეს ნიღბები ნამდვილი აღმოჩენაა ჩემთვის. ატენიანებს, კვებავს და აგლუვებს კანს
ზამთარში ყველაზე პოპულარული და სასარგებლო ხილია მანდარინი. უგემრიელესი და წვნიანი ხილი ვიტამინების ბუნებრივი წყაროა. გაჯერებულია მჟავეებით, ეთეროვანი ზეთებით და სხვა სასარგებლო ნივთიერებებით. მანდარინის წვენი აუმჯობესებს მეტაბოლურ პროცესებს.
მანდარინის ქერქი მდიდარია კაროტინით, ორგანული მჟავებით და ეთერზეთებით....
წელის და ხერხემლის ტკივილი გაწუხებთ? 3 ხილის ჩირი, რომელიც დაგეხმარებათ პრობლემის მოგვარებაში
შეგაწუხათ ზურგის, მუხლების, სახსრების ტკივილმა, ანემიამ, ყაბზობამ ან ჯანმრთელობასთან დაკავშირებულმა სხვა პრობლემებმა? გირჩევთ, მოძებნოთ მარტივი და უსაფრთხო გამოსავალი, რომელიც შეგიმსუბუქებთ ტკივილს, დაგეხმარებათ ხერხემლისა და სახსრების შემაერთებელი ქსოვილის აღდგენაში, გაგიუმჯობესებთ მხედველობას, საჭმლის მომნელებელი ტრაქტის ფუნქციონირებას,...
ჭარხლის გემრიელი სალათიც რეცეპტი, რომელიც უებარია მთელი სხეულისთვის. აღადგენს მხედველობას, წმენდს ნაწლავებს და სტიმულირებს...
თუ გსურთ, გაიწმინდოთ ნაწლავები ნარჩენებისგან, ღვიძლი ზედმეტი ცხიმისგან, გაიუმჯობესოთ მხედველობა და ჯანმრთელობის საერთო მდგომარეობა დაამატეთ თქვენი კვების რაციონს ჭარხალი.
უამრავი საკვები ნივთიერებით დატვირთული ჭარხალი აუმჯობესებს სისხლის მიმოქცევას, აძლიერებს გულ-სისხლძარღვთა სისტემას, გმატებთ ენერგიას.
ჭარხალი შეიცავს ბეტაინს და...
შეგაწუხათ ძლიერმა ხველამ? სამკომპონენტიანი მარტივი საშინაო რეცეპტი უებარია
შემოგთავაზებთ ბუნებრივი ინგრედიენტებით მომზადებული ხველის საწინააღმდეგო ხელნაკეთი წამლის რეცეპტს. მოცემული საშუალების წყალობით შეძლებთ იმუნური სისტემის გაძლიერებას. წამლის მიღება დასაშვებია ნებისმიერი ასაკის ადამიანისთვის.
უამრავი სასარგებლო საკვები ნივთიერებით მდიდარი თაფლი გაჯერებულია ანტიბაქტერიული, ანტივირუსული და სოკოს საწინააღმდეგო თვისებებით....
მუცლის შებერილობა და ყაბზობა გაწუხებთ? 4 მარტივი რეცეპტი გაგათავისუფლებთ ამ პრობლემისგან
თუ თქვენ გაწუხებთ ყაბზობა, შებერილობა და დარღვეული გაქვთ საჭმლის მომნელებელი სისტემის ფუნქციონირება, აუცილებლად დაგაინტერესებთ სტატიაში შემოთავაზებული რეცეპტები.
მოცემული რეცეპტების მიხედვით ჩაის ამზადებთ სამკურნალო მცენარეებით.
1. ძირა, ქინძი, კამა
ძირის, ქინძისა და კამის თესლების კომბინაცია ამშვიდებს კუჭს და...
თევზის კატლეტები ყველით. ეს რეცეპტი ნამდვილი აღმოჩენაა, განსაკუთრებით კი თევზის მოყვარულთათვის
შემოგთავაზებთ გემრიელი და სასარგებლო კერძის რეცეპტს. თევზის კატლეტი მოსამზადებლად უმარტივესია და მზადდება ძალიან სწრაფად.
მოსამზადებლად დაგჭირდებათ შემდეგი ინგრედიენტები:
თევზის ფილე 250 გრ
კარაქი 60 გრ
ხმელი ყველი 60 გრ
შავი პილპილი გემოვნებით
მარილი გემოვნებით
რეჰანი...